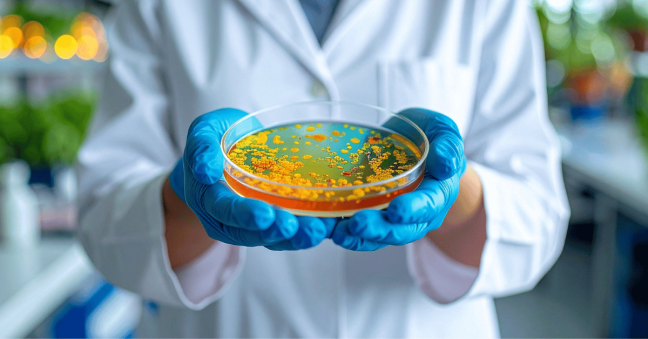
Spooky Science: Uncovering the Creepiest Compounds, Proteins & Processes!

Spooky Science: Uncovering the Creepiest Compounds, Proteins & Processes!
As Halloween approaches, we’re uncovering the spooky side of science! From vampire bats to zombie cells, our collection of eerie molecules, petrifying proteins, and terrifyingly fun scientific terms are guaranteed to give your lab the chills this month. Happy Halloween from the team at Hello Bio!